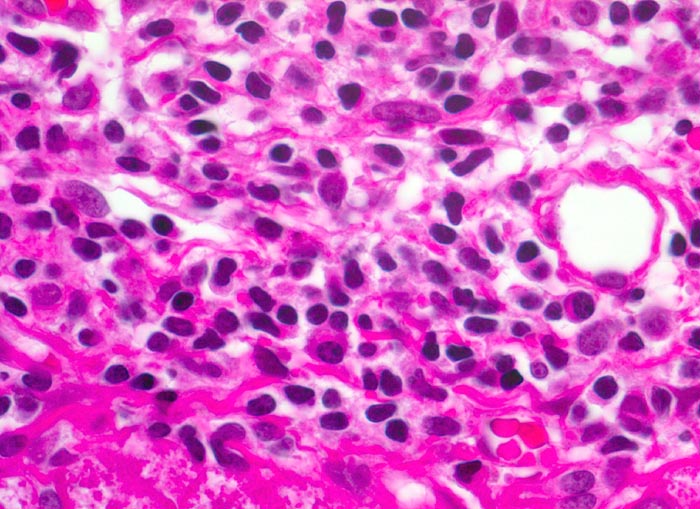

PathoPic – image database / PathoPic ID 4965 - chronische Hepatitis C mit geringgradiger Aktivität
de
Diagnose
chronische Hepatitis C mit geringgradiger Aktivität
Diagnose Gruppe
Entzündung infektiös
Topographie
Leber
Topographie Gruppe
Leber, Gallenwege, Pankreas
Beschreibung
Zusatzbefund
Fibrose der Portalfelder mit portoportaler Septenbildung.
Klinik
Intravenöser Drogenabusus vor 10 Jahren. Damals Infektion mit dem Hepatitis C Virus.
Kommentar
Das Entzündungsinfiltrat bei chronischer viraler Hepatitis ist zusammengesetzt aus mononukleären Zellen. Vereinzelt lassen sich auch wenige eosinophile Granulozyten nachweisen. Neutrophile Granulozyten sind nicht nachweisbar.
Bilder Typ
Histologie
Vergrösserung
630
Alter
36
Geschlecht
männlich
Datum
Ersteintrag: 12.06.2002
Update: 04.02.2024